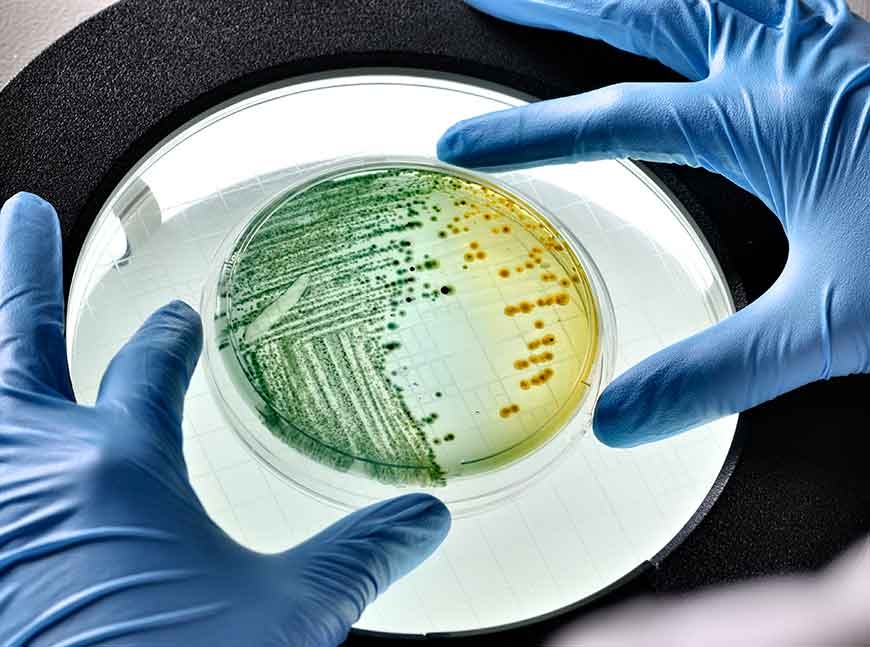
Avient推出含抗菌添加剂的GLS™ TPE新产品

科莱恩推出用于建筑涂料的低VOC颜料分散体
- 其他行业- 阅 188
搜料网资讯: 近日,科莱恩推出全系列Hostatint AU水性颜料分散体,扩大了外部和内部建筑涂料的色彩选择。让北美和拉丁美洲的制造商有能力提供最广泛的调色板。 新的低VOC、不含AP...
【信易集团】水油两用模具控温机STM-W/O
- 其他行业- 阅 206
搜料网资讯: 、...
安全、性能稳定的新型婴儿奶瓶
- 其他行业- 阅 152
搜料网资讯: ●婴儿用品制造商 Zoom T 使用 Ultrason P 3010 材料,通过挤出吹塑工艺生产曲线型奶瓶 ●巴斯夫的透明聚苯砜强度高,且耐高温蒸汽 位于东京的日本婴儿用品制造商 Zoom T 如...
Avient推出含抗菌添加剂的GLS™ TPE新产品
- 其他行业- 阅 131
搜料网资讯: Avient近日宣布在其GLS TPE产品组合中增加了三种含有抗菌添加剂的TPE专有配方。根据JIS Z2801和ASTM G21-15标准测试,这些添加剂通过抑制细菌生长(99.9%以上)和抵抗真菌和霉...
科莱恩推出低VOC建筑涂料颜料分散体
- 其他行业- 阅 164
搜料网资讯: ● 颜色没有界限--客户现在可以选择任何颜色,从传统的色调到真正可定制的色调,而没有批次不一致的情况。 ● 通用的、高性能的、低VOC的水性颜料分散体,设计用于...
3D打印技术将掀自动化建房革命?美媒这么说
- 3D打印- 阅 162
搜料网资讯: 据美联社近日报道,新一代初创企业希望利用工业3D打印机实现自动化建房,以此改变房屋的建造方式。 报道介绍,3D打印又称增材制造,利用机器将塑料、金属、混凝土...
北京冬奥会将实现100%清洁能源供电
- 其他行业- 阅 260
搜料网资讯: 随着冬奥倒计时的滴答声响,第24届冬季奥林匹克运动会各项涉奥工程在紧锣密鼓地高效推进。绿色办奥是北京冬奥会的重要理念之一,全部场馆100%使用清洁能源供电更将...
Teknor Apex推出新的尼龙化合物 用于汽车和电子产品
- 汽车交通- 阅 115
搜料网资讯: 近日,位于R.I. Pawtucket的Teknor Apex公司高管在一份新闻稿中说,这些新的Creamid品牌材料不含卤素,具有阻燃性和玻璃强化功能。与标准的玻璃填充的阻燃尼龙66相比,这些化...
汉高开发出业界首个用于消费电子组装的生物基PUR热熔胶
- 电子电器- 阅 203
搜料网资讯: 汉高利用其广泛的创新组合,并与公司的可持续发展优先事项保持一致,近日宣布开发并商业化供应LOCTITE HHD 3544F,这是业界首个为消费电子组装设计的生物基 聚氨酯 反应...
真正的3D打印连续碳纤维复合材料
- 3D打印- 阅 163
搜料网资讯: Electroimpact公司开发了一种拥有6个自由度的连续纤维增强热塑性塑料3D打印系统,能实现航空复合材料部件的快速无模制造,以及现有制造方法不可能实现的新的设计自由度...
梅赛德斯-奔驰与UBQ Materials获得汽车可持续发展奖
- 汽车交通- 阅 224
搜料网资讯: UBQ Materials公司和梅赛德斯-奔驰公司被提名为今年首届汽车可持续发展奖的获得者,该奖项由Springer Fachmedien的ATZ/MTZ集团和罗兰贝格管理咨询有限公司联合举办,属于最佳初...
巴斯夫助力婴儿用品制造商打造健康安全奶瓶
- 其他行业- 阅 282
搜料网资讯: 近日, 位于东京的日本婴儿用品制造商Zoom T使用 巴斯夫 的 聚苯砜 ( PPSU ) Ult rason P 热塑性材料生产Dr. Btta(蓓特、蓓特博士、贝塔博士)的婴儿奶瓶。 聚苯砜(PPSU)符合...
东南亚石化业出现复苏迹象
- 其他行业- 阅 245
搜料网资讯: 东南亚石化业正缓慢从新冠肺炎疫情中复苏。今年已有一些新项目投产,随着需求改善和供应受限,石化品价格也在不断上涨。尽管存在不确定性,该地区仍有多个大型扩...
科思创推出由回收PET制成的3D打印材料
- 3D打印- 阅 213
搜料网资讯: 材料制造商科思创介绍了其最近从DSM收购的增材制造业务所开发的第一种材料:一种用于3D颗粒打印的玻璃纤维填充的回收聚对苯二甲酸乙二醇酯(rPET)。Arnite AM2001 GF (...

搜料网资讯: 新测试证实Actizone F5 可为被处理表面提供24小时出色抗病毒保护,对抗SARS-CoV-2等包膜病毒 布鲁塞尔,2021年3月30日 索尔维的即用型 Actizone F5 消毒剂现已经过验证,可为多种...
